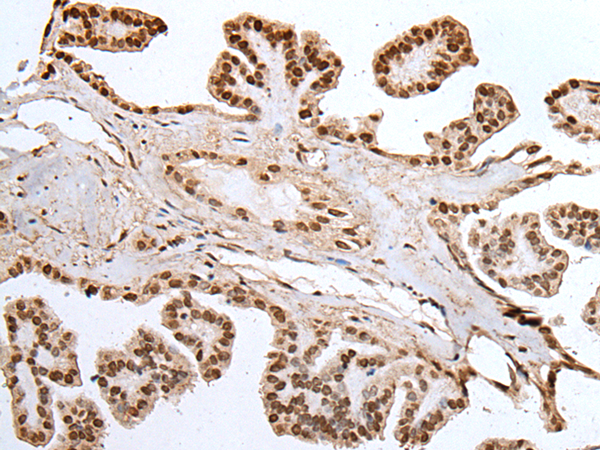

中文名稱: 兔抗MEF2D多克隆抗體
英文名稱: Anti-MEF2D rabbit polyclonal antibody
相關類別: 一抗
儲 存: 冷凍(-20℃)
宿 主: Rabbit
抗 原: MEF2D
反應種屬: Human, Mouse, Rat
標 記 物: Unconjugate
克隆類型: rabbit polyclonal
技術規格
|
Background: |
This gene is a member of the myocyte-specific enhancer factor 2 (MEF2) family of transcription factors. Members of this family are involved in control of muscle and neuronal cell differentiation and development, and are regulated by class II histone deacetylases. Fusions of the encoded protein with Deleted in Azoospermia-Associated Protein 1 (DAZAP1) due to a translocation have been found in an acute lymphoblastic leukemia cell line, suggesting a role in leukemogenesis. The encoded protein may also be involved in Parkinson disease and myotonic dystrophy. Alternative splicing results in multiple transcript variants. |
|
Applications: |
ELISA, IHC |
|
Name of antibody: |
MEF2D |
|
Immunogen: |
Synthetic peptide of human MEF2D |
|
Full name: |
myocyte enhancer factor 2D |
|
SwissProt: |
Q14814 |
|
ELISA Recommended dilution: |
5000-10000 |
|
IHC positive control: |
Human esophagus cancer and human thyroid cancer |
|
IHC Recommend dilution: |
25-100 |

購物車
幫助
021-54845833/15800441009
